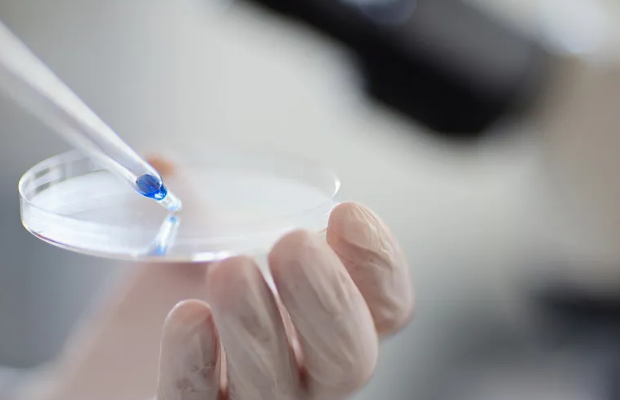
image.png

干細(xì)胞肺癌治療臨床效果評(píng)估
2024-09-01 16:03:06 來(lái)源: 小編 咨詢醫(yī)生
一、干細(xì)胞治療的原理與機(jī)制
干細(xì)胞治療是一種利用干細(xì)胞的再生與分化能力,調(diào)節(jié)體內(nèi)微環(huán)境,恢復(fù)組織功能的新興醫(yī)療手段。肺癌作為全球發(fā)病率和死亡率最高的癌癥之一,傳統(tǒng)治療手段如放療、化療及手術(shù)等常常存在局限性。而干細(xì)胞治療通過(guò)其天然的修復(fù)能力,能夠幫助改善肺癌患者的生活質(zhì)量,甚至在部分病例中實(shí)現(xiàn)臨床療效。
1. 促進(jìn)細(xì)胞再生
干細(xì)胞能夠分化為多種類型的細(xì)胞,并支持受損組織的再生。肺癌患者的肺組織通常受損嚴(yán)重,干細(xì)胞的注入能夠刺激肺組織修復(fù),并可能抑制腫瘤生長(zhǎng)。
2. 調(diào)節(jié)免疫反應(yīng)
干細(xì)胞具有免疫調(diào)節(jié)作用,可以調(diào)節(jié)局部和全身的免疫反應(yīng),增強(qiáng)機(jī)體對(duì)腫瘤細(xì)胞的識(shí)別與清除能力。這對(duì)于降低腫瘤轉(zhuǎn)移風(fēng)險(xiǎn)以及增強(qiáng)患者的整體免疫力具有重要意義。
3. 分泌生長(zhǎng)因子
干細(xì)胞能夠分泌多種生長(zhǎng)因子(如 VEGF、bFGF),這些因子不僅促進(jìn)血管新生,還能改善腫瘤微環(huán)境,使腫瘤的生長(zhǎng)受抑制。
二、目前臨床研究進(jìn)展
自干細(xì)胞治療肺癌的研究開(kāi)展以來(lái),多個(gè)臨床試驗(yàn)逐漸揭示了其潛在的療效和安全性。
1. 基礎(chǔ)研究成果
研究顯示,特定類型的干細(xì)胞(如間充質(zhì)干細(xì)胞 MSCs)能夠在肺癌模型中有效抑制腫瘤生長(zhǎng),并展示出更好的安全性。這些研究為臨床應(yīng)用奠定了基礎(chǔ)。
2. 臨床試驗(yàn)結(jié)果
多項(xiàng)臨床試驗(yàn)正在進(jìn)行中,初步結(jié)果顯示經(jīng)過(guò)干細(xì)胞治療的肺癌患者在生存率和生活質(zhì)量方面有顯著改善。在一些試驗(yàn)中,數(shù)據(jù)表明患者的腫瘤體積減小,呼吸功能得到改善。
3. 患者反饋
患者在接受干細(xì)胞治療后普遍反映出更好的精神狀態(tài)和身體狀況。這表明不僅僅是治療效果的提高,患者的總體生活質(zhì)量也得到了改善。
三、干細(xì)胞治療的挑戰(zhàn)與前景
盡管干細(xì)胞治療在肺癌的治療中展現(xiàn)出廣闊前景,但仍存在著諸多挑戰(zhàn)。
1. 安全性問(wèn)題
隨著干細(xì)胞技術(shù)的進(jìn)步,如何確保使用的干細(xì)胞來(lái)源安全、有效是一個(gè)重要課題。必須進(jìn)行嚴(yán)格的篩選和檢測(cè),以防止?jié)撛诘哪[瘤生成風(fēng)險(xiǎn)。
2. 標(biāo)準(zhǔn)化治療
當(dāng)前干細(xì)胞治療仍缺乏統(tǒng)一的標(biāo)準(zhǔn)和規(guī)范,不同醫(yī)院、不同研究中心的治療方案存在差異,這影響了療效的可比性和普及性。
3. 長(zhǎng)時(shí)間跟蹤
對(duì)于干細(xì)胞治療的長(zhǎng)期效果和潛在副作用,目前的研究數(shù)據(jù)仍顯不足,長(zhǎng)時(shí)間的隨訪研究是未來(lái)的重要方向。
四、總結(jié)
干細(xì)胞肺癌治療作為一種新興的治療方法,正在逐步展示其獨(dú)特的臨床效果和應(yīng)用潛力。隨著科學(xué)技術(shù)的不斷進(jìn)步和臨床研究的深入,干細(xì)胞治療有望為肺癌患者提供更為有效的治療方案,提升生命質(zhì)量。
文章來(lái)源:https://www.2008eshop.cn/ganxibao/37289.html?admin_id=1
-
上一頁(yè): 蘋(píng)果干細(xì)胞的作用原理和實(shí)際運(yùn)用
-
下一頁(yè): 干細(xì)胞治療成功治愈率高嗎,干細(xì)胞治療成功案例
- 2024-08-26干細(xì)胞治療無(wú)精癥,詳解治療流程與費(fèi)用
- 2024-09-20乳牙干細(xì)胞作用是什么,作用原理詳解
- 2024-08-20什么是造血干細(xì)胞移植,造血干細(xì)胞移植的基本流程
- 2024-09-22干細(xì)胞治療肝硬化有效果嗎?費(fèi)用多少
- 2024-11-08干細(xì)胞療法潛在風(fēng)險(xiǎn)有哪些,如何評(píng)估其安全性
- 2024-08-18干細(xì)胞技術(shù)讓牙齒再生,牙齒再生或夢(mèng)想成真
- 2024-09-24干細(xì)胞抗衰老口服膠囊有用嗎,功效與作用詳解
- 2024-07-17臍帶干細(xì)胞有必要存嗎,儲(chǔ)存的價(jià)格及作用介紹
- 2024-10-11干細(xì)胞移植后怎么看效果?如何評(píng)估治療效果?
- 2024-10-05 干細(xì)胞多少毫升才算有效?怎樣選擇合適的治療量?
- 2024-09-07干細(xì)胞能治療哪些疾病,現(xiàn)在干細(xì)胞能治什么病呢
- 2024-09-27骨科干細(xì)胞注射費(fèi)用多少?效果持續(xù)多久?
- 2024-07-18干細(xì)胞對(duì)老年癡呆的改善大嗎,干細(xì)胞改善阿爾茲海默癥的效果
- 2024-08-26廣東干細(xì)胞機(jī)構(gòu)有哪些,廣東干細(xì)胞機(jī)構(gòu)名單公布
- 2024-07-18北京干細(xì)胞移植哪個(gè)醫(yī)院好,北京干細(xì)胞移植醫(yī)院排名分享
- 2024-10-11干細(xì)胞儲(chǔ)存的費(fèi)用是多少?如何確保儲(chǔ)存的安全可靠?
- 2024-08-06存儲(chǔ)干細(xì)胞費(fèi)用,存儲(chǔ)干細(xì)胞有什么用
- 2024-09-20糖尿病干細(xì)胞治療多少錢(qián),哪個(gè)醫(yī)院好
